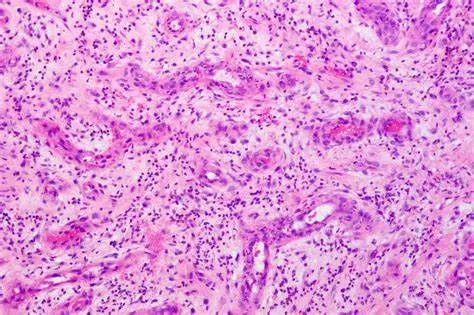

Scars are a general term for the appearance and pathological changes of normal tissues caused by various human tissue damages. They are an inevitable product in the repair process of skin tissue damage; the balance between the synthesis and degradation of collagen in the process of wound healing will be disrupted. The formation of pathological scars.
Trauma is a common phenomenon of skin injury. The repair process of skin after trauma is a very complicated process, including hemostasis and inflammation, regeneration of granulation tissue, proliferation of fibrous tissue, reconstruction of epithelial tissue, wound contraction and many other aspects; And in the whole process of wound repair, it is also affected by genetic factors and environmental factors.

The three stages of scar formation
Generally, we divide the process from skin wound repair to scar formation into three stages: inflammation period, proliferation period, and repair period.
1. Inflammation: When our skin is traumatized, there are different degrees of damage from the epidermis to the dermis, the stratum corneum and the basal layer are broken, the capillaries in the dermal papillary layer are ruptured, blood flows out of the skin, and collagen The fibrous structure is destroyed; then an inflammatory response begins. Among them, prostaglandins, complement factors, interleukin-1 and other factors stimulate the migration of neutrophils and macrophages to debride wounds. TGF-β released by macrophages and platelet-derived growth factors are formed. Temporary wound substrate.

2. Proliferative period: According to the size and depth of the wound, fibroblasts, endothelial cells, and keratinocytes begin to swim around, which marks the beginning of the proliferative period. Fibroblasts stimulate collagen mother cells to produce large amounts of type III and type I collagen, fibronectin and proteoglycan to rebuild damaged fibrous tissue. If the damage is serious, the required collagen fibers will proliferate excessively. Form hyperplastic granulation tissue.

3. Repair period: Finally, keratinocytes initiate the re-epithelialization of the wound through the reconstruction of the membrane matrix. Under the stimulation of hypoxic environment and vascular inflammatory factors in granulation tissue, endothelial cells on the wound surface form new blood vessels to produce blood supply to provide nutrients for the new skin. Early scar formation. When the scar tissue continues to mature, type III collagen The proportion of protein is reduced.

Classification of scars
At present, we can roughly divide the main scars into two categories: physiological scars and pathological scars. The former refers to scars that have no discomfort, no effect on aesthetics, no dysfunction, and no need for treatment. On the contrary, they are pathological scars, which mainly include hyperplastic scars and keloids. According to the color, texture and feeling of the scar, we can subdivide it into seven types:
1. Superficial scars, a kind of scars on the superficial skin, also called flat scars, are mostly caused by surgical sutures, mild burns or superficial infections, and are characterized by different appearance from normal skin, rough surface, and pigment There is usually no dysfunction due to agglomeration or depigmentation, local shallow depression or elevation.

2. Hypertrophic scars can occur at all ages, the location is uncertain, the early burning pain and itching, the color is red and hard, often hyperkeratosis, ulcers and contractures, generally atrophy and stable after one year, its clinical The characteristic is that the lesion is protruding from the surface of the skin but confined to the area of ​​the wound, with obvious proliferation, decline, and mature periods.

3. Atrophic scars are the most unstable scar tissue, also called unstable scars. It often occurs in large-area third-degree burns, especially those deep into the fat layer, which have not undergone skin graft surgery, and only rely on the growth of peripheral epithelium to make the wound healed. After the healing of chronic ulcers in the calf and sole of the foot It is also an atrophic scar.

4. Contracture scars are named after the features of dysfunction caused by scars. They are more common after deep burns are healed. Due to scar contraction, they often lead to changes in appearance and dysfunction.

5. Depressed scars are characterized by the scar tissue causing depressions and deformities on the body surface. Our most common depressed scars are due to the long-term failure to control the inflammation of acne. Needle clearing and bursting of acne lead to the formation of a cavity in the inflamed area. Wait for the skin After healed the scabs, acne pits were formed.

6. Keloid is a special scar characterized by continuous and strong proliferation. It is essentially a fibrous tissue tumor on the skin. The main pathological manifestation is the massive deposition of collagen and matrix components in the scar tissue, which infringes on the surrounding normal Skin, and cannot heal itself in a short period of time. The scar is most likely to appear on the front chest, upper neck, outer ears, shoulders and upper arms. It has a tendency to occur frequently in specific parts and can appear on different parts of the body at the same time.

Generally, patients with keloids have a certain family heredity and scar constitution probability, because keloids often have no obvious relationship with the severity of skin damage, and even minor trauma, such as mosquito bites and needle stick injuries, may cause keloids. The current cause is difficult to conclude, because it does not subside spontaneously, and the recurrence rate is high, requiring multiple treatments.
7. Scars become cancerous, and scar tissues can be transformed into scar cancers, which usually occur in unstable scars, especially when the scars rupture and do not heal for a long time. This pathological scar cancer is mostly squamous cell carcinoma, and a small part is basal cell carcinoma. Fortunately, cancer cells are surrounded by the basal and surrounding tough and dense scar fibrous tissue, so they are generally not prone to spread and metastasis.

Causes and mechanisms of scars
Let’s take hyperplastic scars and keloids as examples to illustrate that in general pathological scars, the excessive growth of scar tissue may be related to excessive matrix deposition and reduced collagen degradation.
During the formation of keloids, fibroblasts show abnormal responses to stimulation, and the level of collagen synthesis is excessively enhanced, especially type I collagen. In contrast, fibroblasts in hyperplastic scars respond normally to growth factors, which is manifested by a moderate increase in collagen synthesis.
Transforming growth factor TGF-β induces collagen increase and fibronectin deposition, which is closely related to the pathogenesis of scar hyperplasia. In this type of scar, it is found that the arrangement of collagen fibers is spiral ring and transparent bundle.
In the mature stage of scars, vascular regeneration usually no longer occurs, while keloids and hypertrophic scars in the hyperplastic stage show continuous hyperemia due to continuous new blood vessel formation; therefore, the scars will become larger and larger, and the key point of treatment is To inhibit blood supply from blood vessels.
Other factors that affect the development of hyperplastic scars and keloids include hyaluronic acid, proteoglycans, mast cells and so on. So to sum up, hyperplastic scars and keloids are caused by excessive collagen deposition, abnormal telangiectasia and excessive hyperemia, leading to the formation of scar tissue, while atrophic scars are on the contrary, their connective tissue is destroyed, accompanied by skin atrophy. And fibrosis.
![]()